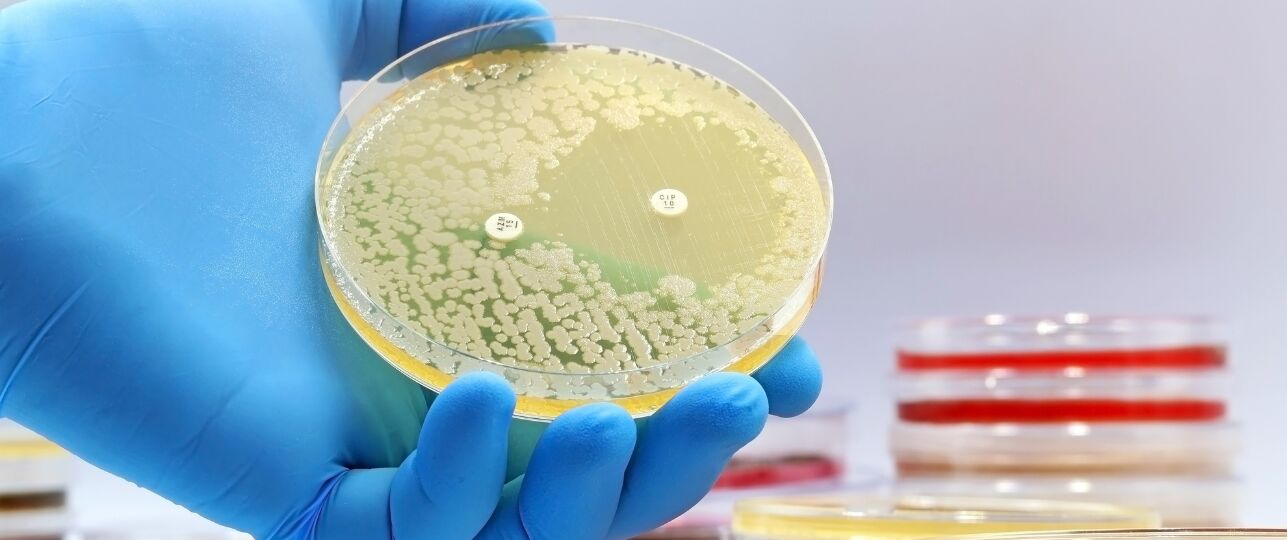
antibioticum

Bron: © Canva.
Bron: © Canva.
Een revolutionair nieuw antibioticum zorgt wereldwijd voor een doorbraak in de medische wetenschap. Onderzoekers van de University of Warwick in Groot-Brittannië hebben per toeval een krachtige nieuwe verbinding ontdekt, die mogelijk een grote rol gaat spelen in de strijd tegen infectiesziektes.
We staan nog aan het begin, maar deze ontdekking bewijst dat zelfs oude bacteriën nieuwe geheimen kunnen bevatten
Vondst met enorme impact
Onderzoekers ontdekten een stof die tot nu toe over het hoofd was gezien. Uit testen blijkt het nieuwe antibioticum 10 tot 100 keer sterker te werken, meldt Warwick University.
Volgens professor Gregory Challis van Warwick laat een experiment zien dat wetenschappers altijd aannemen dat het eindproduct het sterkste antibioticum is. “Deze ontdekking toont aan dat ook tussenproducten verrassend effectief zijn”, aldus Challis.
In vervolgonderzoek zagen wetenschappers dat bacteriën veel minder snel resistent werden tegen deze nieuwe stof. “Dat maakt het stofje extra interessant in een tijd waarin steeds meer infecties moeilijker te behandelen zijn”, bevestigt ScienceAlert.
Nieuw wapen in de strijd
Resistente bacteriën vormen een wereldwijd groeiend probleem. Infecties die vroeger eenvoudig te genezen waren, reageren vaak niet meer op bestaande medicijnen.
De ontdekking van dit nieuwe antibioticum betekent dat er mogelijk opnieuw een wapen beschikbaar komt tegen bacteriën waar tot nu toe geen effectief middel tegen bestond. In laboratoriumtests bleek bijvoorbeeld dat slechts 1 microgram van het nieuwe antibioticum al voldoende was om bepaalde resistente bacteriën te doden, terwijl van oudere middelen wel 256 microgram nodig waren, aldus GEN Edge.
Wat dit betekent dit voor onze gezondheid
Wie ooit een hardnekkige blaasontsteking of luchtweginfectie heeft gehad die niet goed reageerde op antibiotica, weet hoe frustrerend en zorgwekkend dat kan zijn. De ontdekking van sterkere antibiotica, kan in betekenen dat zulke infecties beter te behandelen zijn en dat ziekenhuisopnames door resistente bacteriën afnemen.
Toch is voorzichtigheid geboden. Het middel is tot nu toe alleen getest in het laboratorium. Er moeten nog proeven en klinische onderzoeken plaatsvinden voordat het veilig op mensen kan worden toegepast. “We staan nog aan het begin, maar deze ontdekking bewijst dat zelfs oude bacteriën nieuwe geheimen kunnen bevatten”, stelt Challis.
Lees verder onder het bericht >>
Antibiotica zijn levensreddend, maar resistentie vormt een groeiend probleem. Onze arts-microbiologen Edwina Doting en Geesje Roo-Brand beantwoorden in deze video vijf veel gestelde vragen over antibtiotica. #WAAW2024 #WAAW #AntibioticaResistentie #BewustGebruik #UMCG pic.twitter.com/nH2UDNbmk5
— UMCG (@umcg) November 18, 2024
Zorgvuldig omgaan met bestaande middelen
Tot het nieuwe antibioticum daadwerkelijk op de markt komt, blijft het belangrijk dat we zorgvuldig omgaan met bestaande middelen:
- Gebruik antibiotica alleen volgens voorschrift van je arts en maak de kuur altijd af, ook als je je beter voelt.
- Vraag advies bij terugkerende of langdurige infecties, zodat onnodig gebruik van antibiotica kan worden voorkomen.
Enthousiaste reacties
Veel mensen enthousiast op het nieuws. Op wetenschapsfora en nieuwspagina’s wordt de ontdekking geprezen. ScienceAlert noemt het ‘opmerkelijk dat deze bacterie al sinds de jaren 50 wordt onderzocht. Het vinden van een nieuw antibioticum is een echte verrassing.’
Tegelijk waarschuwen sommige gebruikers dat het nog om vroege laboratoriumresultaten gaat. “Geweldig nieuws, maar laten we realistisch blijven: de weg naar een goedgekeurd medicijn is nog lang”, schrijft iemand op X.
Volgende stappen in het onderzoek
De wetenschappers van Warwick en Monash University hebben aangekondigd dat de volgende onderzoeksfase uit drie stappen bestaat:
- Preklinisch onderzoek om de veiligheid en werkzaamheid in diermodellen te testen.
- Ontwikkeling van analogen, oftewel chemisch verwante stoffen die mogelijk nog sterker of stabieler zijn.
- Klinische studies bij mensen, als eerdere tests succesvol zijn.
Volgens de onderzoekers kan de vondst ook het wetenschappelijke denken veranderen. Het loont om tussenproducten in de productie van antibiotica opnieuw te onderzoeken, in plaats van alleen de eindproducten te bestuderen. Dat idee zou de zoektocht naar nieuwe medicijnen aanzienlijk kunnen versnellen, stelt ScienceAlert.
Toeval in de wetenschap
Deze ontdekking toont ook de waarde van nieuwsgierigheid in fundamenteel onderzoek. Het was immers een PhD-student die besloot de tussenstof te testen, iets wat oorspronkelijk niet in het onderzoeksplan stond. Zonder dat experiment was de uitzonderlijke kracht van deze verbinding waarschijnlijk onopgemerkt gebleven.
Het bewijst dat toeval en doorbraak vaak hand in hand gaan. “Het is een herinnering dat zelfs in bekende biologische systemen nog onverwachte parels te vinden zijn”, aldus Nature.
Bron:
Nature